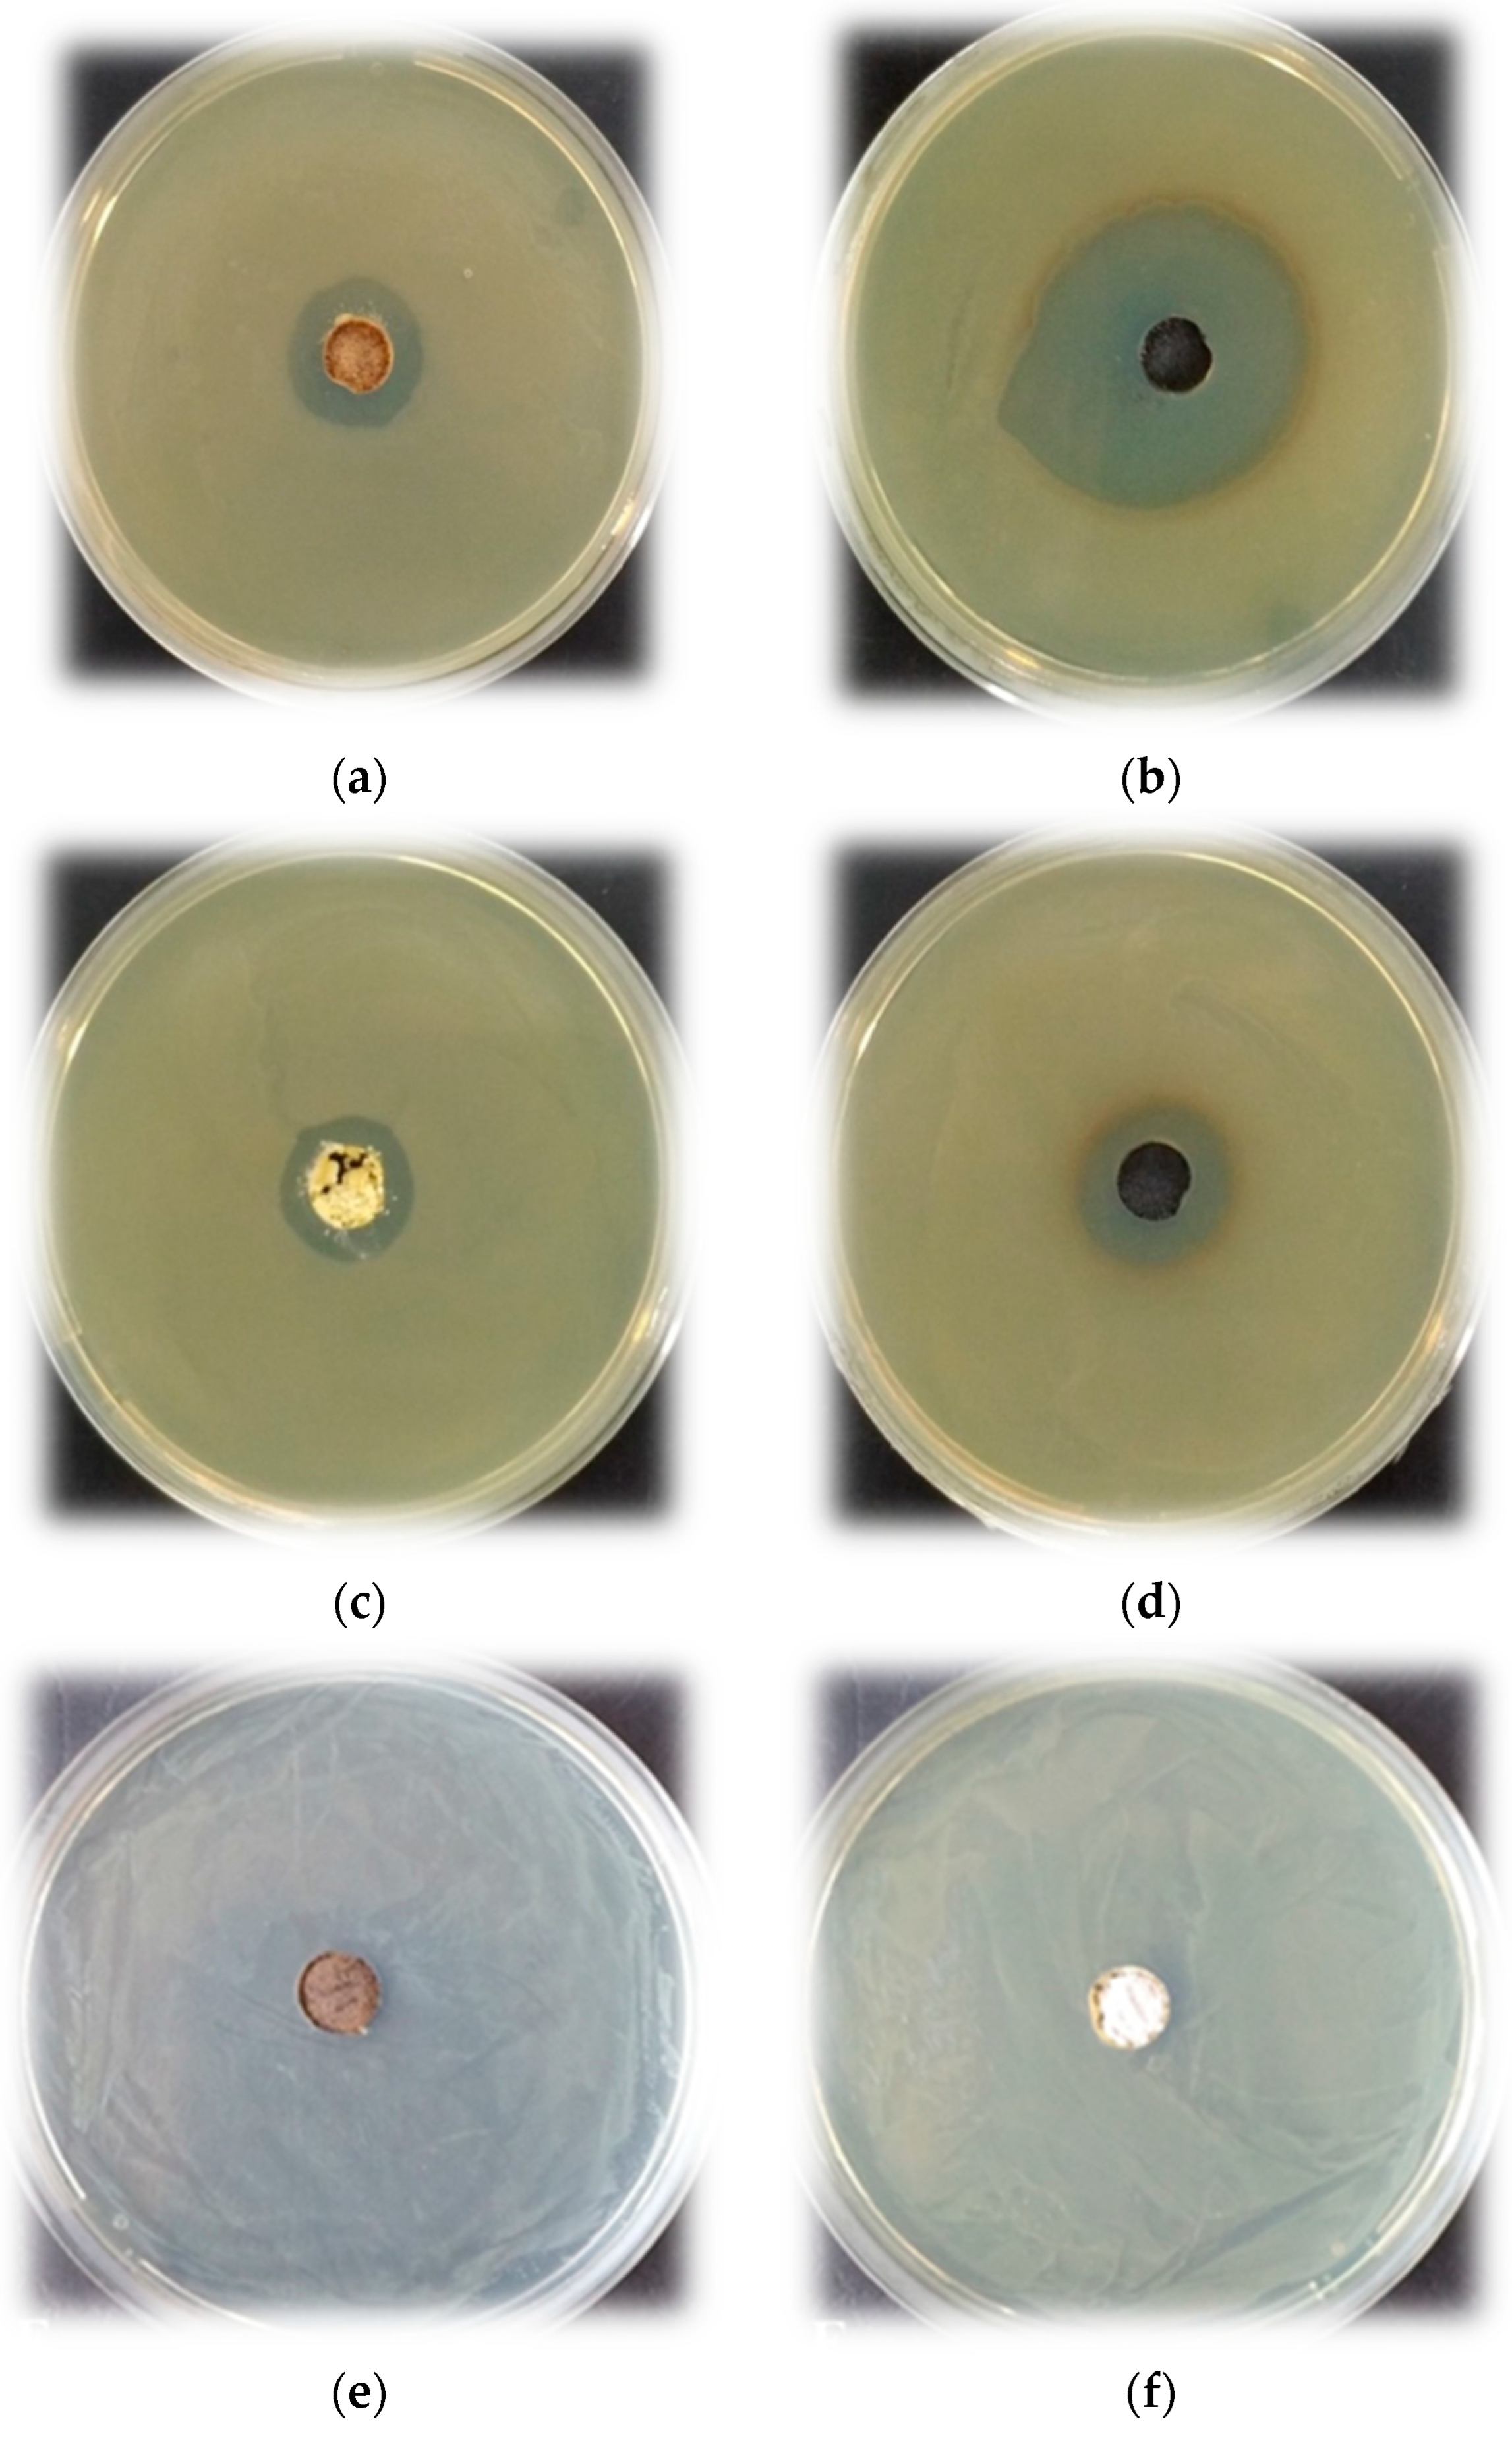
Materials 16 06400 g007

Effect of B2O3 on the Structure, Properties and Antibacterial Abilities of Sol-Gel-Derived TiO2/TeO2/B2O3 Powders
Abstract
:1. Introduction
2. Materials and Methods
2.1. Gelling and Drying
2.2. Sample Characterization
2.2.1. Photocatalysis
2.2.2. Antibacterial Properties
Test Microorganisms, Media and Culture Conditions
Bactericidal Effect of the Investigated Materials
3. Results and Discussion
3.1. Phase Formation Studies and Thermal Stability of the Gels
3.2. SEM Morphology
3.3. Structural Change IR and UV-Vis Spectra
3.3.1. IR Investigations
3.3.2. UV-Vis Investigations
3.4. UV Photocatalytic Properties
3.5. Antibacterial Properties
4. Conclusions
Author Contributions
Funding
Institutional Review Board Statement
Informed Consent Statement
Data Availability Statement
Acknowledgments
Conflicts of Interest
References
- Pye, L.D.; Fréchette, V.D.; Kreidl, N.J. Borate Glasses: Structure, Properties, Applications; Springer: New York, NY, USA, 1978. [Google Scholar]
- Abou Neel, E.A.; Pickup, D.M.; Valappil, S.P.; Newport, R.J.; Knowles, J.C. Bioactive functional materials: A perspective on phosphate-based glasses. J. Mater. Chem. 2009, 19, 690–701. [Google Scholar] [CrossRef]
- Balasubramanian, P.; Büttner, T.; Miguez Pacheco, V.; Boccaccini, A.R. Boron-containing bioactive glasses in bone and soft tissue engineering. J. Eur. Ceram. Soc. 2018, 38, 855–869. [Google Scholar] [CrossRef]
- Lepry, W.C.; Nazhat, S.N. A Review of Phosphate and Borate Sol–gel Glasses for Biomedical Applications. Adv. NanoBiomed Res. 2021, 1, 2000055. [Google Scholar] [CrossRef]
- Yamashita, H.; Yoko, T.; Sakka, T. Preparation of Li2B4O7 thin films by Sol–gel method. J. Mater. Sci. Lett. 1990, 9, 796–798. [Google Scholar] [CrossRef]
- Hirano, S.; Yogo, T.; Kikuta, K.; Yamagiwa, K. Preparation of β-BaB2O4 Powders and Thin Films by Sol–Gel Method. J. Amer. Cer. Soc. 1992, 75, 2590–2592. [Google Scholar] [CrossRef]
- Nogami, M.; Moriya, Y. Glass formation of the SiO2-B2O3 system by the gel process from metal alkoxides. J. Non-Cryst. Solids 1982, 48, 359–366. [Google Scholar] [CrossRef]
- Tohge, N.; Matsuda, A.; Minami, T. Coating Films of 20B2O3.80SiO2 by the Sol–gel Method. J. Am. Ceram. Soc. 1987, 70, 13–15. [Google Scholar] [CrossRef]
- Villegas, M.A.; Fernandez Navarro, J.M. Characterization of B2O3-SiO2 glasses prepared via Sol–gel. J. Mater. Sci. 1988, 23, 2464–2478. [Google Scholar] [CrossRef]
- Irwin, A.; Holmgren, J.; Jonas, J. Solid state 29Si and 11B NMR studies of Sol–gel derived borosilicates. J. Non-Cryst. Solids 1988, 101, 249–254. [Google Scholar] [CrossRef]
- Abe, Y.; Gunji, T.; Kimata, K.; Kuramata, M.; Kasgoz, A.; Misono, T. Preparation of polymetalloxanes as a precursor for oxide ceramics. J. Non-Cryst. Solids 1990, 121, 21–25. [Google Scholar] [CrossRef]
- Weinberg, M.C.; Neilson, G.F.; Smith, G.L.; Dunn, B.; Moore, G.S.; Mackenzie, J.D. The preparation and characterization of a lithium borate glass prepared by the gel technique. J. Mater. Sci. 1985, 20, 1501–1508. [Google Scholar] [CrossRef]
- Tohge, N.; Moore, G.S.; Mackenzie, J.D. Part III. Preparation of multicomponent gels and glasses. Structural developments during the gel to glass transition. J. Non-Cryst. Solids 1984, 63, 95–103. [Google Scholar] [CrossRef]
- Ciceo, R.L.; Trandafir, D.L.; Radu, T.; Pota, O.; Simon, V. Synthesis, characterisation and in vitro evaluation of sol–gel derived SiO2–P2O5–CaO–B2O3 bioactive system. Ceram. Int. 2014, 40, 9517–9524. [Google Scholar] [CrossRef]
- Gerganova, T.; Ivanova, Y.; Gerganov, T.; Miranda Salvado, I.M.; Fernandes, M.H.V. The Sol–Gel Process: Uniformity, Polymers and Applications; Morris, R.E., Ed.; Chapter 13; Nova Science Publishers, Inc.: Hauppauge, NY, USA, 2010. [Google Scholar]
- Xue, X.; Wang, Y.; Yang, H. Preparation and characterization of boron-doped titania nano-materials with antibacterial activity. Appl. Surf. Sci. 2013, 264, 94–99. [Google Scholar] [CrossRef]
- Rehman, S.; Ullah, R.; Butt, A.; Gohar, N. Strategies of making TiO2 and ZnO visible light active. J. Hazard. Mater. 2009, 170, 560–569. [Google Scholar] [CrossRef]
- Jung, K.; Park, S.; Ihm, S. Local structure and photocatalytic activity of B2O3–SiO2/TiO2 ternary mixed oxides prepared by sol–gel method. Appl. Catal. B Environ. 2004, 51, 239–245. [Google Scholar] [CrossRef]
- Moon, S.C.; Mametsuka, H.; Suzuki, E.; Nakahara, Y. Characterization of titanium-boron binary oxides and their photocatalytic activity for stoichiometric decomposition of water. Catal. Today 1998, 45, 79–84. [Google Scholar] [CrossRef]
- Sakka, S. Handbook of Sol–Gel Science and Technology: Processing, Characterization and Applications; Vols. I, II and III.; Kluwer Academic Publishers: Dordrecht, The Netherlands, 2004. [Google Scholar]
- Brinker, C.J.; Scherer, G. Sol–Gel Science: The Physics and Chemistry of Sol–Gel Processing; Academic Press Inc.: San Diego, CA, USA, 1990. [Google Scholar]
- Soulis, M.; Mirgorodsky, A.P.; Merle-Méjean, T.; Masson, O.; Thomas, P.; Udovic, M. The role of modifier’s cation valence in structural properties of TeO2-based glasses. J. Non-Cryst. Solids 2008, 354, 143–149. [Google Scholar] [CrossRef]
- Udovic, M.; Thomas, P.; Mirgorodsky, A.; Durand, O.; Soulis, M.; Masson, O.; Merle-Méjean, T.; Champarnaud-Mesjard, J.C. Thermal characteristics, Raman spectra and structural properties of new tellurite glasses within the Bi2O3–TiO2–TeO2 system. J. Solid State Chem. 2006, 179, 3252–3259. [Google Scholar] [CrossRef]
- El-Malawany, R. Tellurite Glasses, Physical Properties and Data; CRC Press: Boca Raton, FL, USA, 2002. [Google Scholar]
- Umar, S.A.; Halimah, M.K.; Azlan, M.N.; Grema, L.U.; Ibrahim, G.G.; Ahmad, A.F.; Hamza, A.M.; Dihom, M.M. Structural, elastic and thermo-physical properties of Er2O3 nanoparticles doped bio-silicate borotellurite glasses. SN Appl. Sci. 2020, 2, 291. [Google Scholar] [CrossRef]
- Umar, S.A.; Halimah, M.K.; Chan, K.T.; Amirah, A.A.; Azlan, M.N.; Grema, L.U.; Hamza, A.M.; Ibrahim, G.G. Optical and structural properties of rice husk silicate incorporated borotellurite glasses doped with erbium oxide nanoparticles. J. Mater. Sci. Mater. Electron. 2019, 30, 18606–18616. [Google Scholar] [CrossRef]
- Iordanova, R.; Bachvarova-Nedelcheva, A.; Gegova, R.; Dimitriev, Y. Sol–gel synthesis of composite powders in the TiO2-TeO2-SeO2 system. J. Sol–Gel Sci. Technol. 2016, 79, 12–28. [Google Scholar] [CrossRef]
- Iordanova, R.; Gegova, R.; Bachvarova-Nedelcheva, A.; Dimitriev, Y. Sol–gel synthesis of composites in the ternary TiO2-TeO2-B2O3 system. Phys. Chem. Glasses Eur. J. Glass Sci. Technol. B 2015, 56, 128–138. [Google Scholar] [CrossRef]
- Bachvarova-Nedelcheva, A.; Iordanova, R.; Gegova, R.; Dimitriev, Y. Sol–gel synthesis and optical characterization of TiO2/TeO2 powders. Bulg. Chem. Commun. 2016, 48, 5–10. [Google Scholar]
- Bachvarova-Nedelcheva, A.; Iordanova, R.; Gegova, R.; Dimitriev, Y. Crystallization of gels in the binary TiO2-MnOm (MnOm = TeO2, SeO2, B2O3, ZnO) systems. Bulg. Chem. Commun. 2017, 49, 110–118. [Google Scholar]
- Bachvarova-Nedelcheva, A.; Iordanova, R.; Kostov, K.L.; Gegova, R. Sol–gel powder synthesis in the TiO2-TeO2-ZnO system: Structural characterization and properties. Arab. J. Chem. 2020, 13, 7132–7146. [Google Scholar] [CrossRef]
- Bachvarova-Nedelcheva, A.; Iordanova, R.; Naydenov, A.; Stoyanova, A.; Georgieva, N.; Nemska, V.; Foteva, T. Sol–gel obtaining of TiO2/TeO2 nanopowders with biocidal and environmental applications. Catalysts 2023, 13, 257. [Google Scholar] [CrossRef]
- Bachvarova-Nedelcheva, A.; Iordanova, R.; Georgieva, N.; Nemska, V.; Stoyanova, A. Photocatalytic and antibacterial assessment of Sol–gel derived TiO2/TeO2/ZnO powders. J. Chem. Technol. Metall. 2022, 57, 589–597. [Google Scholar]
- Bachvarova-Nedelcheva, A.; Iordanova, R.; Stoyanova, A.; Georgieva, N.; Angelova, T. Sol–gel synthesis of Se and Te containing TiO2 nanocomposites with photocatalytic and antibacterial properties. J. Optoel. Adv. Mater. 2016, 18, 5–9. [Google Scholar]
- Shalaby, A.; Bachvarova-Nedelcheva, A.; Iordanova, R.; Dimitriev, Y.; Stoyanova, A.; Hitkova, H.; Ivanova, N. Sol–gel synthesis and properties of nanocomposites in the Ag/TiO2/ZnO system. J. Optoel. Adv. Mater. 2015, 17, 248–256. [Google Scholar]
- Lecomte, A.; Bamiere, F.; Coste, S.; Thomas, P.; Champarnaud-Mesjard, J.C. Sol–gel processing of TeO2 thin films from citric acid stabilised tellurium isopropoxide precursor. J. Europ. Cer. Soc. 2007, 27, 1151–1158. [Google Scholar] [CrossRef]
- Weng, L.; Hodgson, S. Sol–gel processing of tellurite materials from tellurium ethoxide precursor. Mater. Sci. Eng. 2001, 87, 77–82. [Google Scholar] [CrossRef]
- Valgas, C.; de Souza, S.M.; Smania, E.F.A., Jr. Screening methods to determine antibacterial activity of natural products. Braz. J. Microbiol. 2007, 38, 369–380. [Google Scholar] [CrossRef]
- Hayakawa, T.; Koyama, H.; Nogami, M.; Thomas, P. Optical properties of TeO2-TiO2 thin films doped with Eu3+ ions fabricated by Sol–gel processing. J. Univ. Chem. Technol. Metall. 2012, 47, 381–386. [Google Scholar]
- Weng, L.; Hodgson, S. Multicomponent tellurite thin film materials with high refractive index. Opt. Mater. 2002, 19, 313–317. [Google Scholar] [CrossRef]
- Velasco, M.J.; Rubio, F.; Rubio, J.; Oteo, J.L. FT-IR Study of the Hydrolysis and Polymerization of Tetraethyl Orthosilicate and Polydimethyl Siloxane in the Presence of Tetrabutyl Orthotitanate. Spectr. Lett. 1999, 32, 289–304. [Google Scholar] [CrossRef]
- Yordanov, S.I.; Bachvarova-Nedelcheva, A.D.; Iordanova, R.S. Influence of ethylene glycol on the hydrolysis-condensation behavior of Ti(IV) butoxide. Bulg. Chem. Commun. 2017, 49, 265–270. [Google Scholar]
- Dubey, R.S.; Krishnamurthy, K.V.; Singh, S. Experimental studies of TiO2 nanoparticles synthesized by Sol–gel and solvothermal routes for DSSCs application. Results Phys. 2019, 14, 102390. [Google Scholar] [CrossRef]
- Doeuff, S.; Henry, M.; Sanchez, C.; Livage, J. Hydrolysis of titanium alkoxides: Modification of the molecular precursor by acetic acid. J. Non-Cryst. Solids 1987, 89, 206–216. [Google Scholar] [CrossRef]
- Uzunova-Bujnova, M.; Dimitrov, D.; Radev, D.; Bojinova, A.; Todorovsky, D. Effect of the mechanoactivation on the structure, sorption and photocatalytic properties of titanium dioxide. Mater. Chem. Phys. 2008, 110, 291–298. [Google Scholar] [CrossRef]
- Crisan, M.; Zaharescu, M.; Crisan, D.; Ion, R.; Manolache, M. Vanadium Doped Sol–gel TiO2 Coatings. J. Sol–Gel Sci. Technol. 1998, 13, 775–778. [Google Scholar] [CrossRef]
- Arnaudov, M.; Dimitrov, V.; Dimitriev, Y.; Markova, L. Infrared-spectral investigation of tellurites. Mater. Res. Bull. 1982, 17, 1121–1129. [Google Scholar] [CrossRef]
- Shashikala, M.N.; Elizabeth, S.; Cary, B.; Bhat, H.L. Raman and infrared spectroscopic studies of the new ferroelectric crystal telluric acid ammonium phosphate. Curr. Sci. 1987, 56, 861–863. [Google Scholar]
- Nakamoto, K. IR and Raman Spectra of Inorganic Coordination Compounds, 3rd ed.; John and Wiley and Sons: Hoboken, NJ, USA, 1978; p. 230. [Google Scholar]
- Kamitsos, E.; Patsis, A.P.; Karakassides, M.A.; Chryssikos, G.D. Infrared Reflectance Spectra of Lithium Borate Glasses. J. Non-Cryst. Solids 1990, 126, 52–67. [Google Scholar] [CrossRef]
- Varsamis, C.; Kamitsos, E.I.; Chryssikos, G.D. Structure of fast-ion-conducting Ag I-doped borate glasses in bulk and thin film forms. Phys. Rev. B 1999, 60, 3885–3898. [Google Scholar] [CrossRef]
- Kapoutsis, J.A.; Kamitsos, E.I.; Chryssikos, G.D. Synthesis and vibrational investigation of lithium magnesium metaborate glasses. Phys. Chem. Glasses 2000, 41, 321–324. [Google Scholar]
- Soraru, G.D.; Babonneau, F.; Gervais, C.; Dallabona, N. Hybrid RSiO1.5/B2O3 Gels from Modified Silicon Alkoxides and Boric Acid. J. Sol–Gel Sci. Technol. 2000, 18, 11–19. [Google Scholar] [CrossRef]
- Hsieh, C.W.; Chiang, A.S.; Lee, C.C.; Yang, S.J. Preparation of TiO2B2O3 coating by the sol-gel method. J. Non-Cryst. Solids 1992, 144, 53–62. [Google Scholar] [CrossRef]
- Leustic, A.; Babonneau, F.; Livage, J. Structural investigations of the hydrolysis-condensation process ot titanium alkoxides Ti(OR)4 (OR=OPri, OEt) modified by AcAc, 1. Study of the alkoxide modification. Chem. Mater. 1989, 1, 240–247. [Google Scholar] [CrossRef]
- Leustic, A.; Babonneau, F.; Livage, J. Structural investigations of the hydrolysis-condensation process ot titanium alkoxides Ti(OR)4 (OR=OPri, OEt) modified by AcAc, 2. From the modified precursor to the colloids. Chem. Mater. 1989, 1, 248–252. [Google Scholar] [CrossRef]
- Siwinska-Stefanska, K.; Zdarta, J.; Paukszta, D.; Jesionowski, T. The influence of addition of a catalyst and chelating agent on the properties of titanium dioxide synthesized via the Sol–gel method. J. Sol–Gel Sci. Technol. 2015, 75, 264–278. [Google Scholar] [CrossRef]
- Yao, Z.Y.; Möncke, D.; Kamitsos, E.I.; Houizot, P.; Celarie, F.; Rouxel, T.; Wondraczek, L. Structure and mechanical properties of copper-lead and copper-zinc borate glasses. J. Non-Cryst. Solids 2016, 435, 55–68. [Google Scholar] [CrossRef]
- Iordanova, R.; Milanova, M.; Aleksandrov, L.; Khanna, A. Structural study of glasses in the system B2O3-Bi2O3-La2O3-WO3. J. Non-Cryst. Solids 2018, 481, 254–259. [Google Scholar] [CrossRef]
- Kamitsos, E.I.; Karakassides, M.A.; Chryssikos, G.D. Vibrational spectra of magnesium-sodium-borate glasses. Raman and mid-infrared investigation of the network structure. J. Phys. Chem. 1987, 91, 1073–1079. [Google Scholar] [CrossRef]
- Barlier, V.; Bounor-Legare, V.; Boiteux, G.; Davenas, J. Hydrolysis-condensation reactions of titanium alkoxides in thin films: A study of the steric hindrance effect by X-ray photoelectron spectroscopy. Appl. Surf. Sci. 2008, 254, 5408–5412. [Google Scholar] [CrossRef]
- Saidi, W.; Rasheed, M.; Hfayedh, N.; Girtan, M.; El Maaoui, M.; Megriche, A. Effect of B2O3 addition on optical and structural properties of TiO2 as a new blocking layer for multiple dye sensitive solar cell application (DSSC). RSC Adv. 2016, 6, 68819–68826. [Google Scholar] [CrossRef]
- Zaleska, A.; Sobczak, J.W.; Grabowska, E. and Hupka, Photocatalytic activity of boron-modified TiO2 under visible light: The effect of boron content, calcination temperature and TiO2 matrix. J. Appl. Catal. B 2008, 78, 92–100. [Google Scholar] [CrossRef]
- Tijani, J.O.; Momoh, U.O.; Salau, R.B.; Bankole, M.T.; Abdulkareem, A.S.; Roos, W.D. Synthesis and characterization of Ag2O/B2O3/TiO2 ternary nanocomposites for photocatalytic mineralization of local dyeing wastewater under artificial and natural sunlight irradiation. Environ. Sci. Pollut. Res. 2019, 26, 19942–19967. [Google Scholar] [CrossRef]
- Zaleska, A. Doped—TiO2: A Review. Recent Pat. Eng. 2008, 2, 157–164. [Google Scholar] [CrossRef]
- May-Lozano, M.; López-Medina, R.; Rojas-García, E.; Hernández-Pérez, I.; Martínez-Delgadillo, S.A. Characterization of B-TiO2 Synthesized under Different Conditions of Hydrolysis. J. Adv. Oxid. Technol. 2016, 19, 326–337. [Google Scholar] [CrossRef]
- Soylu, N.Y.; Soylu, A.; Dikmetas, D.N.; Karbancioglu-Guler, F.; Kucukbayrak, S.; Taygun, M.E. Photocatalytic and Antimicrobial Properties of Electrospun TiO2–SiO2–Al2O3–ZrO2–CaO–CeO2 Ceramic Membranes. ACS Omega 2023, 8, 10836–10850. [Google Scholar] [CrossRef] [PubMed]
- Gu, Q.; Zhao, W.; Yuan, J.; Yao, Y.; Wang, Y.; Wu, W. Adsorption and Photodegradation Behaviors of In-Situ Growth TiO2 Films with Various Nano-Structures. Chem. Phys. Lett. 2019, 736, 136804. [Google Scholar] [CrossRef]
- Wang, Y.; Xue, X.; Yang, H. Synthesis and Antimicrobial Activity of Boron-doped Titania Nano-materials, Materials and product engineering. Chin. J. Chem. Eng. 2014, 22, 474–479. [Google Scholar] [CrossRef]
- Yang, H.; Wang, Y.; Xue, X. Influences of glycerol as an efficient doping agent on crystal structure and antibacterial activity of B-TiO2 nano-materials. Colloids Surf. B Biointerfaces 2014, 122, 701–708. [Google Scholar] [CrossRef] [PubMed]
- Wang, Y.Z.; Wu, Y.S.; Xue, X.X.; Yang, H.; Liu, Z.H. Microstructure and antibacterial activity of ions (Ce, Y, or B)-doped Zn-TiO2: A comparative study. Mater. Technol. 2016, 32, 310–320. [Google Scholar] [CrossRef]

| Composition, mol% | Cut-off, nm | Eg, eV |
|---|---|---|
| Ti(IV) n-butoxide | 389.71 | 3.18 |
| TiO2 | 382.73 | 3.23 |
| 80TiO2.10TeO2.10B2O3 (sample B) | 431.09 | 2.88 |
| 80TiO2.20B2O3 (sample C) | 385.86 | 3.21 |
| 50TiO2.25TeO2.25B2O3 (sample A) | 358.19 | 3.46 |
Disclaimer/Publisher’s Note: The statements, opinions and data contained in all publications are solely those of the individual author(s) and contributor(s) and not of MDPI and/or the editor(s). MDPI and/or the editor(s) disclaim responsibility for any injury to people or property resulting from any ideas, methods, instructions or products referred to in the content. |
© 2023 by the authors. Licensee MDPI, Basel, Switzerland. This article is an open access article distributed under the terms and conditions of the Creative Commons Attribution (CC BY) license (https://creativecommons.org/licenses/by/4.0/).
Share and Cite
Bachvarova-Nedelcheva, A.; Iordanova, R.; Stoyanova, A.; Georgieva, N.; Nemska, V.; Foteva, T. Effect of B2O3 on the Structure, Properties and Antibacterial Abilities of Sol-Gel-Derived TiO2/TeO2/B2O3 Powders. Materials 2023, 16, 6400. https://doi.org/10.3390/ma16196400
Bachvarova-Nedelcheva A, Iordanova R, Stoyanova A, Georgieva N, Nemska V, Foteva T. Effect of B2O3 on the Structure, Properties and Antibacterial Abilities of Sol-Gel-Derived TiO2/TeO2/B2O3 Powders. Materials. 2023; 16(19):6400. https://doi.org/10.3390/ma16196400
Chicago/Turabian StyleBachvarova-Nedelcheva, Albena, Reni Iordanova, Angelina Stoyanova, Nelly Georgieva, Veronica Nemska, and Tsvetelina Foteva. 2023. "Effect of B2O3 on the Structure, Properties and Antibacterial Abilities of Sol-Gel-Derived TiO2/TeO2/B2O3 Powders" Materials 16, no. 19: 6400. https://doi.org/10.3390/ma16196400
APA StyleBachvarova-Nedelcheva, A., Iordanova, R., Stoyanova, A., Georgieva, N., Nemska, V., & Foteva, T. (2023). Effect of B2O3 on the Structure, Properties and Antibacterial Abilities of Sol-Gel-Derived TiO2/TeO2/B2O3 Powders. Materials, 16(19), 6400. https://doi.org/10.3390/ma16196400

